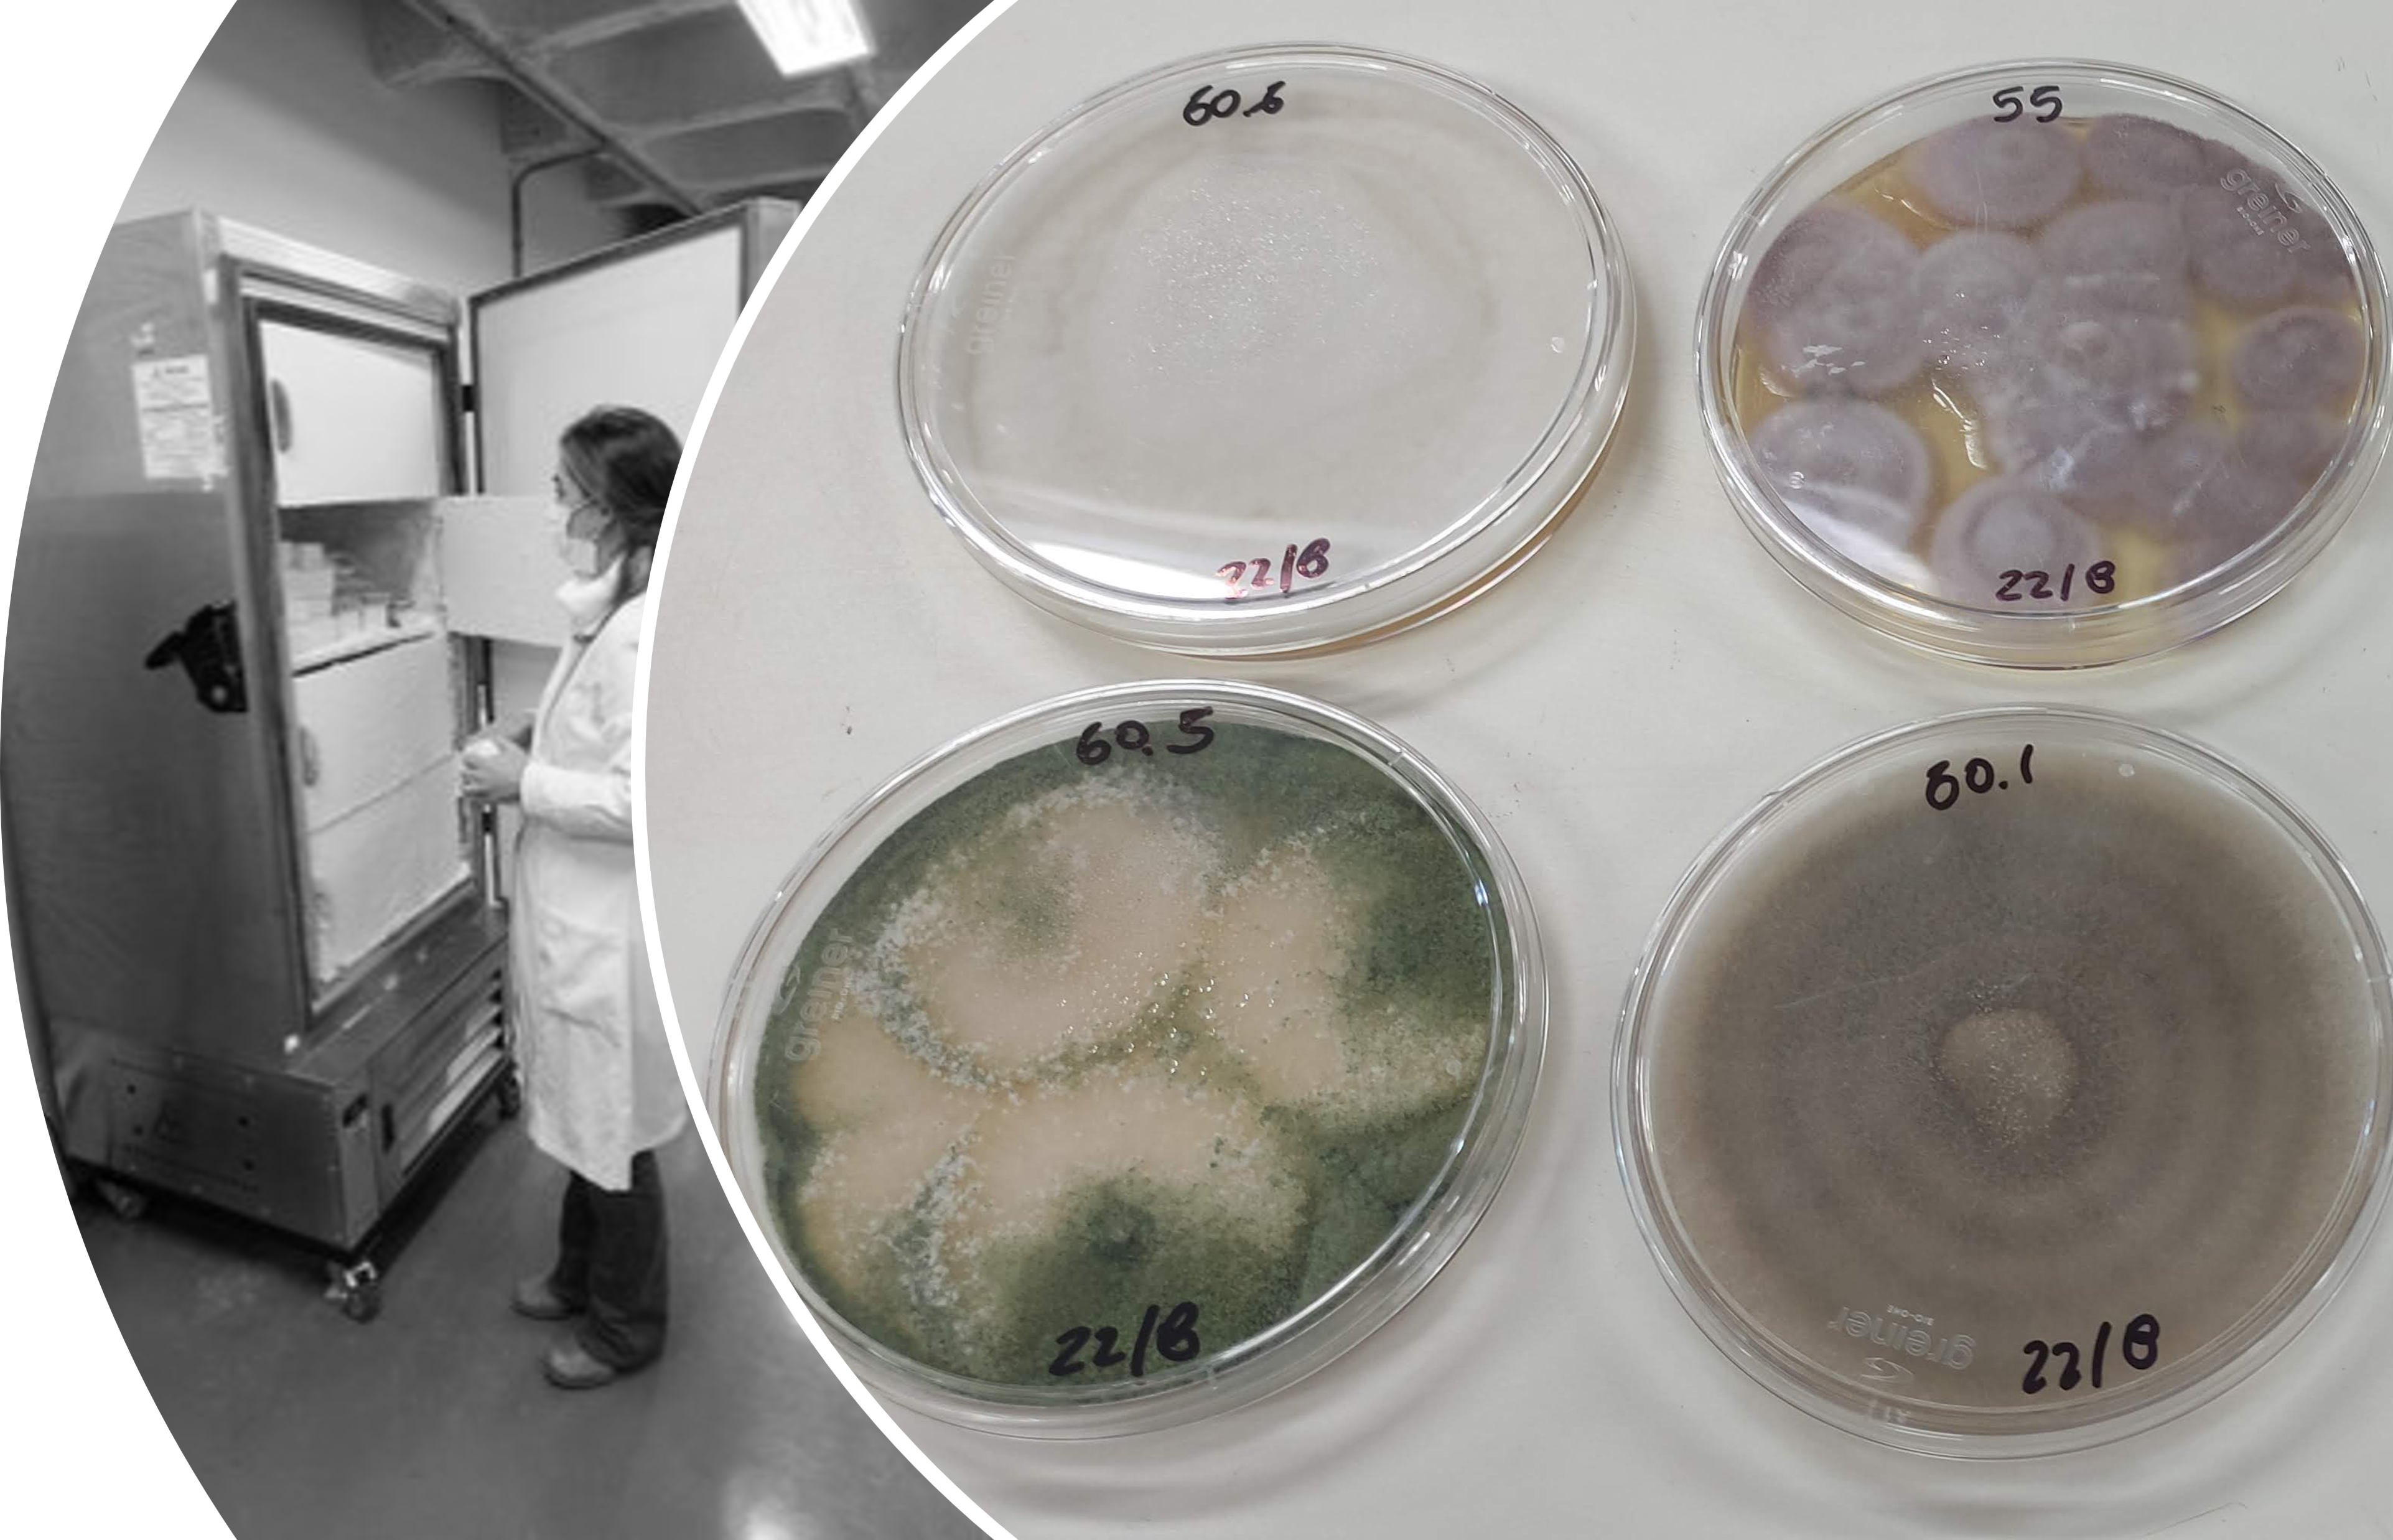

Coleção de Cultura de Microrganismos de Importância Biotecnológica e Ambiental(CCMIBA)
A Coleção de Cultura de Microrganismos de Importância Biotecnológica e Ambiental (CCMIBA) é uma coleção científica institucional dedicada à preservação, caracterização, manutenção e disponibilização de microrganismos com potencial biotecnológico, ambiental e acadêmico. A coleção abriga linhagens bacterianas, fúngicas e outros microrganismos de interesse, atuando como infraestrutura estratégica para pesquisa, ensino, inovação e formação de recursos humanos na área de microbiologia e biotecnologia.
A CCMIBA está alocada nos espaços laboratoriais G008, G009 e G11, localizados no prédio do Jardim Universitário da UNILA.
Os espaços laboratoriais que abrigam a coleção configuram-se como ambiente multiusuário, atendendo especialmente aos cursos de graduação em Biotecnologia e Ciências Biológicas e aos Programas de Pós-Graduação da área de Biologia. Além disso, oferecem suporte a pesquisadores de outras áreas e institutos da universidade.
As atividades desenvolvidas nesses laboratórios contemplam pesquisas em microbiologia geral, ecologia microbiana e microbiologia do solo. Na área de parasitologia, são realizados exames parasitológicos para diagnóstico de helmintoses e protozooses. Em imunologia, os laboratórios apoiam pesquisas relacionadas à imunidade celular e humoral frente a diferentes doenças humanas e animais, incluindo a realização de diagnósticos sorológicos.
Os espaços laboratoriais também dão suporte às atividades de ensino, especialmente em procedimentos de isolamento, identificação, preservação, organização e manutenção de linhagens microbianas e parasitológicas, fortalecendo a integração entre coleção biológica, pesquisa científica e formação acadêmica.